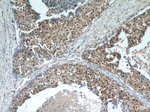
MDC1 Antibody in Immunohistochemistry (Paraffin) (IHC (P))

Search
Proteintech
MDC1 Polyclonal Antibody
{{$productOrderCtrl.translations['antibody.pdp.commerceCard.promotion.promotions']}}
{{$productOrderCtrl.translations['antibody.pdp.commerceCard.promotion.viewpromo']}}
{{$productOrderCtrl.translations['antibody.pdp.commerceCard.promotion.promocode']}}: {{promo.promoCode}} {{promo.promoTitle}} {{promo.promoDescription}}. {{$productOrderCtrl.translations['antibody.pdp.commerceCard.promotion.learnmore']}}
产品信息
24721-1-AP
种属反应
已发表种属
宿主/亚型
分类
类型
抗原
偶联物
形式
浓度
规格
纯化类型
保存液
内含物
保存条件
运输条件
产品详细信息
Immunogen sequence: MEDTQAIDW DVEEEEETEQ SSESLRCNVE PVGRLHIFSG AHGPEKDFPL HLGKNVVGRM PDCSVALPFP SISKQHAEIE ILAWDKAPIL RDCGSLNGTQ ILRPPKVLSP GVSHRLRDQE LILFADLLCQ YHRLDVSLPF VSRGPLTVEE TPRVQGETQP QRLLLAEDSE EEVDFLSERR MVKKSRTTSS SVIVPESDEE GHSPVLGGLG PPFAFNLNSD TDVEEGQQPA TEEASSAARR GATVEAKQSE AEVVTEIQLE KDQPLVKERD NDTKVKRGAG NGVVPAGVIL ERSQPPGEDS DTDVDDDSRP PGRPAEVHLE RAQPFGFIDS DTDAEEERIP ATPVVIPMKK R (1-350 aa encoded by BC152556)
靶标信息
MDC1 participates in the early response to DNA damage. It is thought to be a member of the BRCT (BRCA1 C-terminus) super family of nuclear proteins. It contains an N-terminus forkhead-associated (FHA) motif, two C-terminus BRCT motifs and 13 internal repetitions of a 41 amino acid sequence.
仅用于科研。不用于诊断过程。未经明确授权不得转售。
生物信息学
蛋白别名: DAAP-285E11.7; DKFZp781A0122; homologue to Drosophila photoreceptor protein calphotin; KIAA0170; Mediator of DNA damage checkpoint protein 1; MGC166888; Nuclear factor with BRCT domains 1; nuclear protein; unnamed protein product
基因别名: KIAA0170; MDC1; NFBD1
UniProt ID: (Human) Q14676
Entrez Gene ID: (Human) 9656